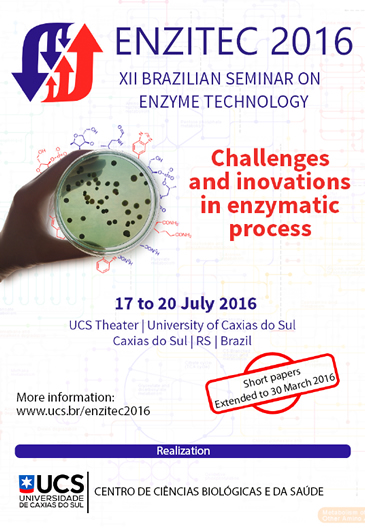

On July 17th to July 20th 2016, Rio Grande do Sul will be hosting the XII Brazilian Seminar on Enzymatic Technology - ENZITEC 2016. University of Caxias do Sul (UCS) will be the responsible for hosting this important scientific event, in Caxias do Sul.
|
Publicize the event. Download the poster. |
We invite the academic community and the business sector to participate in ENZITEC 2016 that will occur in Caxias do Sul, RS, from July 17th to July 20th 2016.
The main purpose of this symposium is to promote an interaction between scientists, professors, students and professionals that are working in the enzymology field in Brazil. The main objective is to present the new research advances related to Applied Enzymology in Brazilian Universities, Institutes and Industries.
Enzymes are used in a wide range of sectors, including human and animal health, chemical and food industry, agriculture, energy and environmental sanitation.
It's relevant to remember the role that the enzymology plays in the sustainable development. In addition, demand for clean technologies, for the utilization of renewable resources and for the challenges of the global climatic change is growing, so we can anticipate an even more development for enzyme utilization in the coming years for many different sectors.
ENZITEC has been occurring every 2 years, occurring at its headquarter where it began, in Rio de Janeiro and for the second time it will be taking place in a different Brazilian state. ENZITEC is the most important event in the Enzymology area of Brazil and it is among the most important ones worldwide.
ENZITEC traditionally has a lot of attendees from Brazil and other countries that register to participate in lectures, short-term courses, debates and many presentations. The participation of exhibitors has been noticeable as well in every edition of this great symposium.
University of Caxias do Sul, represented by the Biotechnology and Process Engineering postgraduate Programs is pleased and honored to promote ENZITEC 2016. This event will have the financial support from state and federal agencies that support research, scientific and technological development, and companies.
Caxias do Sul is known as "Pérola das Colônias". It's gracious, thriving and it has a terrific gastronomy. Caxias attracts a lot of tourists by its metropolis attributes and by its Italian- Southern Brazil tradition, we cannot forget that Caxias do Sul is also remembered by its beauty. Come to visit Caxias do Sul. The city, the University and the population are very glad to welcome you.
For more information enzitec2016@gmail.com or by phone +55 (54) 3218-2100 extension line 2681